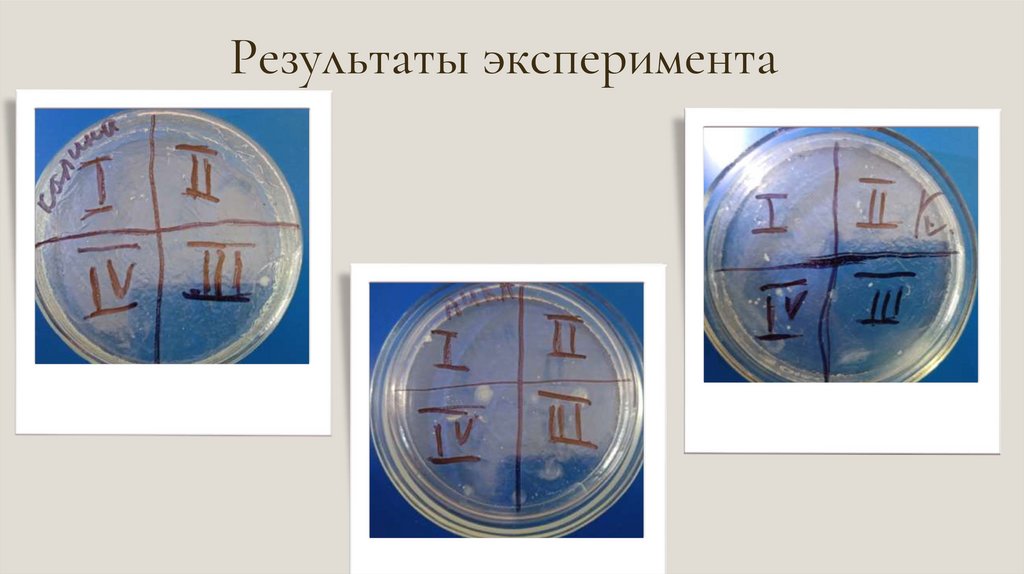

Похожие презентации:
Изучение антисептиков для рук и степени их воздействия на микроорганизмы
1.
Муниципальное бюджетное общеобразовательное учреждение башкирский лицей имениМ.Бурангулова с.Раевский муниципального района Альшеевский район Республики
Башкортостан
«ИЗУЧЕНИЕ АНТИСЕПТИКОВ ДЛЯ РУК И СТЕПЕНИ ИХ ВОЗДЕЙСТВИЯ НА
МИКРООРГАНИЗМЫ»
индивидуальный учебный проект
ВЫПОЛНИЛА:
ученица 10 В класса
Файзрахманова Альбина Фанзилевна
НАУЧНЫЙ РУКОВОДИТЕЛЬ:
учитель биологии
Половникова Елена Владимировна
2.
Актуальность: еще не полностью выяснено как эффективно действуютантисептики на микроорганизмы,поэтому проблема дезинфицирующих
средств остается актуальной.
Цели: изучить антисептические препараты и определить степень их
воздействия на микроорганизмы.
Задачи:
1.Изучить состав антисептиков;
2.Провести социологический опрос об использовании антисептиков;
3.Провести эксперимент по влиянию антисептиков на рост и развитие
микроорганизмов;
Гипотеза: определить эффективность кожных антисептиков возможно в
условиях школьной лаборатории.
3.
Практическая часть.Методы исследования:
• Анкетирование.
• Изучение состава кожных антисептиков.
• Выявление степени эффективности
средств.
(эксперимент, наблюдение)
антисептических
4.
Смывы с рукПосев микроорганизмов методом
истощающего штриха
5.
Результатыанкетирования
6.
Какой фирмой антисептикавы пользуетесь?
Пользуетесь ли вы
антисептиком?
"AURA"
20%
18.8%
31%
"Sanitell
"
6.3%
16.3%
"
10%
69%
"Sanitar"
10%
"Dettol
"
18.8%
7.
Каким видом антисептика выпользуетесь?
Считаете ли вы, что ваш антисептик
защищает вас от микроорганизмов
на 100%?
%
10.4%
12%
9%
38%
22.9%
41%
-80%
19.8%
"
46.9%
8.
Результаты эксперимента9.
10.
Выводы ирекомендации
При
выборе
антисептиков
предпочтение лучше отдавать гелям
или аэрозолям, нежели влажным
салфеткам.
Необходимо обращать внимание на
состав антисептика и лучше выбирать
антисептик на основе спирта.
Если есть возможность, то лучше
воспользоваться старым, проверенным
методом – вымыть руки с мылом, так
как вы не только их обработаете, но и
удалите загрязнения.
Помните – грязные руки источник
болезнетворных микроорганизмов!

Биология
Биология








